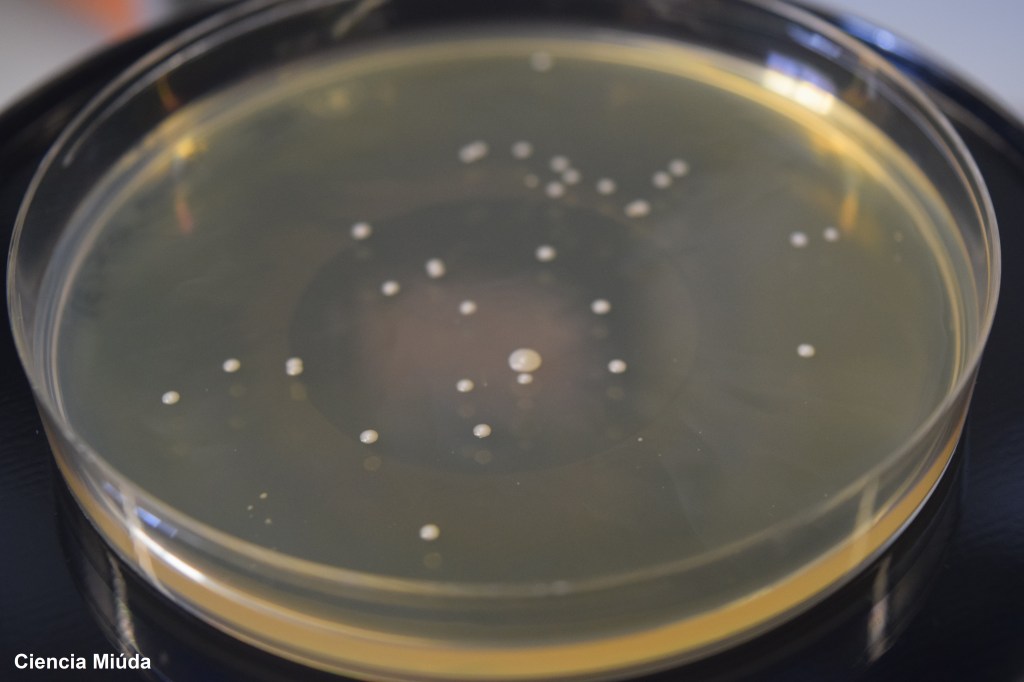

Cada bacteria es un mundo. No es solo que exista una cantidad ingente de bacterias diferentes con formas distintas (y eso que estamos muy lejos de conocerlas todas ya que muchas de ellas aún son incultivables en el laboratorio) sino que además algunos de estos microorganismos pueden cambiar sus características dependiendo del sitio en el que vivan.
Cuando en microbiología necesitamos identificar una bacteria, lo primero que hacemos es aislarla usando una placa de Petri con un medio de cultivo apropiado hasta que se pueda observar una única “unidad formadora de colonia” (UFC): Esta UFC no es otra cosa que el conjunto de células idénticas que proceden de una misma bacteria. En ocasiones, la apariencia de estas colonias, que viene determinada por su borde y su espesor, así como por su consistencia y su textura, puede ser característica de la bacteria.
Pero… ¿Por qué las bacterias tienen la forma que tienen?
Resulta que el tamaño de las colonias bacterianas viene determinado por la necesidad de tener una proporción superficie/volumen muy alto, lo que les facilita el contacto directo con el medio en el que viven favoreciendo la entrada/salida de nutrientes y desechos, así como de información sensorial procedente del exterior. Además, el tamaño de la célula también afecta a la tasa de la actividad metabólica.
Y es que parece mentira que algo tan pequeño como una bacteria tenga tanta ciencia en su interior.

Un comentario sobre “La física de las bacterias”